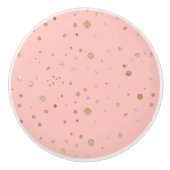
子供部屋ルームピンク赤面とキラキラの円 セラミックノブ (正面)

セラミック取っ手について
販売:
このデザインについて
子供部屋ルームピンク赤面とキラキラの円 セラミックノブ
子供部屋ルームドレッサープルピンクの赤面とキラキラの円。パター人気があるン、照明、枕など、このパターンには様々な子供部屋アイテムがある。私たちは素晴らし子供部屋ルームの装飾の(成長する)選択を持っている、いくつかのコレクションでは、あなたの家の子供部屋のための、またはのためのギフトとして生まれたばかりの。私たちのサイトを訪問してくれてありがとう。お願い後を追だ!
自動翻訳
カスタマーレビュー
この商品についてのレビューは、まだありません。この商品を購入しましたか?
タグ
その他の情報
商品 ID: 256370103388651477
出品日: 2022/2/28 9:51
レーティング: G
最近閲覧された商品